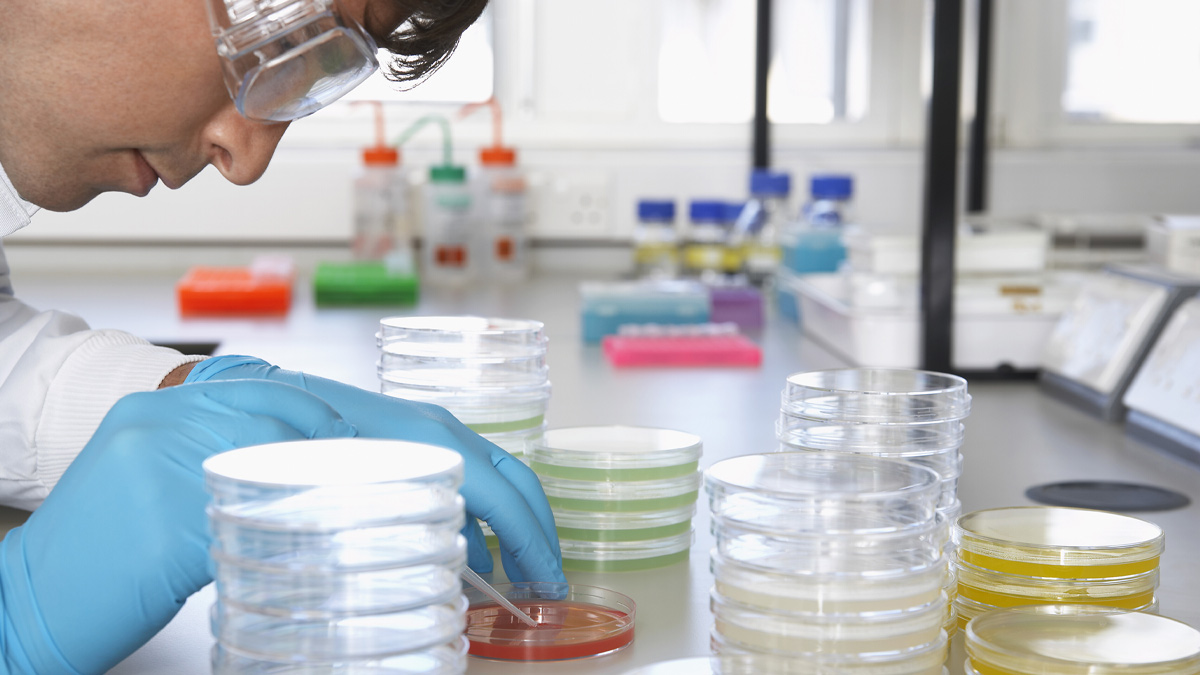
""

About the day
This event is closed for applications.
This free-of-charge event provides a perfect opportunity to learn about the course curriculum and discover what it would be like to study Pharmacy or Pharmacology at degree level. You will have the opportunity to meet current staff and students, as well as explore campus and the benefits of studying at Reading.
Attendees will participate in two taster sessions:
Pharmacy in Action - Think Like a Pharmacist
Ready to jump into the world of pharmacy? Join out interactive taster session where you'll dive into the world of patient care using exciting simulation tools, take on real patient case studies, chat with virtual patients and make key decisions.
Great for aspiring pharmacists and students interested in how technology is reshaping healthcare education, this session is hands-on, high-tech and a whole lot of fun.
Pharmacology - The Science Behind Pain Relief
Ever wondered how pain is sensed and how it can be switched off?
Whether you're curious about neuroscience or drug action, join us for a hands-on session where you'll explore the fascinating world of anaesthetics as a pharmacologist.
In this activity you'll discover how your body detects pain and how anaesthetics interfere with pain signal – no needles involved, just science!
This taster day will be held at our Whiteknights campus and will run from approximately 10:00 – 16:00 (or 17:00 with an optional campus tour), allowing you time to really immerse yourself in the subject and relevant department.
Making the most of your taster day
- Let us know any accessibility requirements when you book your place.
- Check if you’re eligible for a travel bursary.
- Make sure to arrive with plenty of time! You will be sent a schedule for the day about a week before the event.
- Think about what you want to get out of the day, prepare any questions for staff and students.
FAQs
What should I wear for the taster day?
Wear loose, comfortable clothes that cover your legs, and make sure long hair is tied up. Wear sensible shoes (closed toe, no sandals or crocs).
Can I take photos/videos of the experiments?
Yes, but please remove any gloves before handling your phone to avoid cross-contamination, and do not leave your phone in lab coat pockets or on the benchtop,
Can I park on site?
You can park on site for the taster day, but you will need to collect a parking permit and have this displayed in your vehicle for the duration of the event. Parking permits can be collected at the registration point, for more information please email outreach@reading.ac.uk.
Is there somewhere to buy lunch?
We will be providing a free lunch, please make sure you communicate any dietary requirements when you register for the event.

